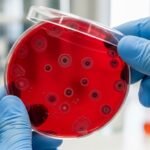

If you have recently returned from a trip to a sun-soaked tropical destination and suddenly find yourself feeling under the weather, malaria might be the last thing on your mind. However, for many travellers and residents in specific regions, a rapid malaria test is the most critical diagnostic tool available for ensuring a safe recovery.
Malaria is a serious and sometimes life-threatening disease, but with early detection, it is highly treatable. In this guide, we will explore how these tests work, what to expect during the process, and why they are a game-changer in the fight against tropical diseases.
What is a rapid malaria test?
A rapid malaria test, often referred to by experts as rapid diagnostic tests (RDTs), is a quick way to determine if malaria parasites are present in a person’s blood. Unlike traditional laboratory methods that require a high-powered microscope and a specialist, these tests can be performed almost anywhere.
These tests work by detecting specific parasite antigens released by malaria parasites, such as Plasmodium falciparum, the most dangerous species of the parasite. According to the NHS, getting a fast diagnosis is the first step toward starting the correct antimalarial treatment.
How does the test work?
The beauty of the rapid malaria test lies in its simplicity. It is a point-of-care diagnostic, meaning it can be used at a bedside, in a remote clinic, or even at a GP surgery. The process typically involves a small finger prick to collect a tiny blood sample.
The sample is placed on a test strip along with a buffer solution. As the liquid moves across the strip, it reacts with antibodies. If the parasite antigens are present, a coloured line appears—much like a lateral flow test for COVID-19 or a pregnancy test. This process aligns with current WHO guidelines for managing the disease in endemic areas.
Step-by-step process:
- The healthcare professional cleans your finger with an alcohol swab.
- A small lancet is used to prick the skin.
- The blood is collected using a tiny pipette.
- The blood and a reagent are added to the test cassette.
- Results are usually visible within 15 to 20 minutes.
Recognising malaria symptoms
Before you seek a rapid malaria test, you should be aware of the common malaria symptoms. These often mimic a severe flu and can appear anywhere from a week to a year after being bitten by an infected mosquito. If you are travelling to a high-risk area, keep an eye out for:
- High temperature (fever) and chills.
- Headaches and muscle aches.
- Nausea, vomiting, and diarrhoea.
- Extreme tiredness (fatigue).
- A general sense of feeling “unwell.”
According to Mayo Clinic, failing to treat these symptoms quickly can lead to complications like severe anaemia or respiratory distress.
Rapid malaria test vs. Microscopy
While the rapid malaria test is incredibly convenient, it is often compared to “gold standard” microscopy. While microscopy allows a technician to determine the exact parasite density in the blood, RDTs offer speed when every minute counts.
The following table compares the two primary methods used by medical researchers and clinicians:
| Feature | Rapid Malaria Test (RDT) | Microscopy (Blood Smear) |
|---|---|---|
| Speed | 15–20 minutes | 60+ minutes |
| Equipment Needed | None (Self-contained) | Microscope & Lab reagents |
| Training Required | Minimal | High (Specialist required) |
| Detects Parasite Density? | No | Yes |
| Accuracy | High for P. falciparum | Highest (Gold Standard) |
Pros and cons of RDTs
Like any medical diagnostic tool, the rapid malaria test has its strengths and limitations. Understanding these helps healthcare providers make the best decisions for patient care.
The Advantages:
- Accessibility: Can be used in rural areas without electricity or laboratories.
- Fast Results: Allows for immediate initiation of antimalarial treatment.
- Simple Interpretation: Clear visible lines make it easy for a healthcare professional to read.
The Limitations:
- Sensitivity: May not detect very low levels of parasites in the blood.
- Persistence: Some tests stay positive for weeks even after the infection is cleared, as reported in Nature.
- Storage: The kits can be sensitive to extreme heat and humidity, which are common in endemic areas.

What happens after the test?
If your rapid malaria test is positive, your doctor will likely prescribe a course of tablets. The type of medication depends on where you were infected and the severity of your symptoms. Organisations like Malaria No More emphasise that finishing the entire course of medication is vital to prevent relapse.
If the test is negative but you still feel unwell, do not ignore it. A healthcare professional may suggest repeating the test or performing a blood smear to ensure the parasite density wasn’t just too low to detect initially. You can find more detailed clinical information on ScienceDirect.
The bottom line
The rapid malaria test has revolutionised how we approach tropical diseases. By providing a fast, reliable, and easy-to-use method for early detection, it saves thousands of lives every year. Whether you are a frequent traveller or living in a high-risk zone, knowing about this tool is essential for your health toolkit. For more health tips, check out Medical News Today or Patient.info.
Frequently Asked Questions (FAQs)
Can I perform a rapid malaria test at home?
While some kits are sold online, it is strongly recommended that a rapid malaria test is performed by a healthcare professional. Proper technique for the finger prick and accurate interpretation of the results are essential for a correct diagnosis. If you suspect malaria, seek medical attention immediately at a clinic or specialist infectious disease centre.
How accurate is a rapid malaria test?
Modern RDTs are highly accurate, particularly for detecting Plasmodium falciparum. However, no test is 100% perfect. Factors like the quality of the kit and the parasite density in the blood sample can affect the outcome. Research published in The Lancet Global Health continues to monitor and improve the efficacy of these tools.
Is the test painful?
The test involves a quick finger prick, which may feel like a tiny pinch or sting for a second. It is a very routine procedure, similar to how people with diabetes check their blood sugar levels. For more on diagnostic innovations, visit PATH.